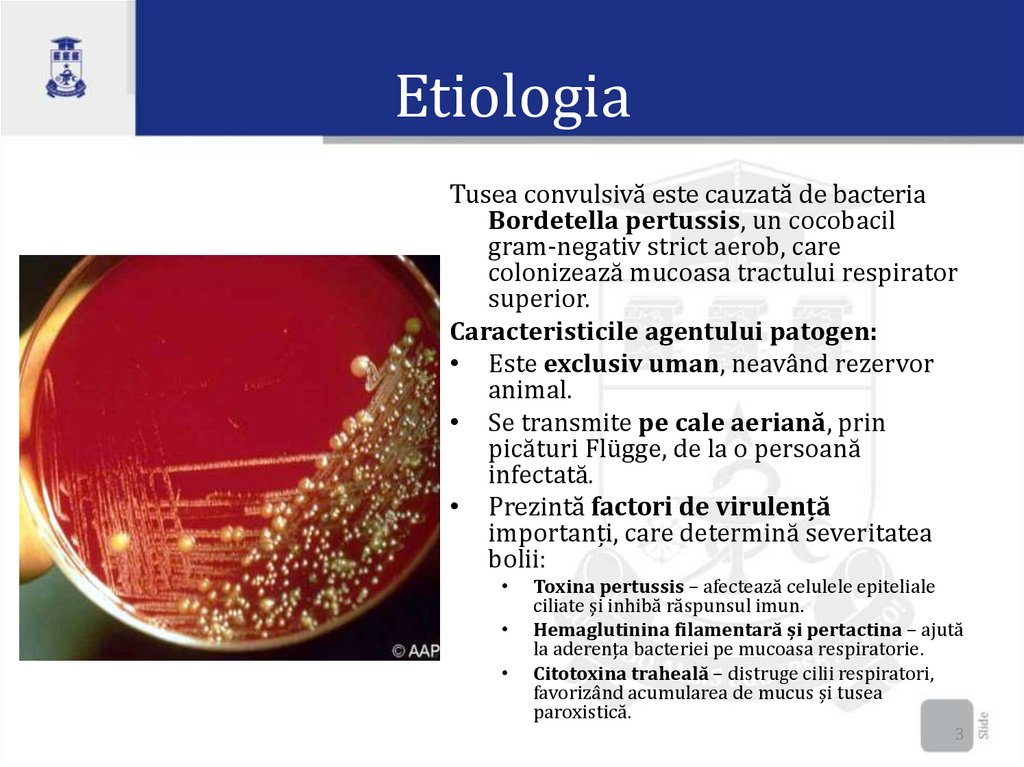

Similar presentations:
Tusea convulsivă
1.
Tusea convulsivăAutor: Tofan Maria
M1929
Coordonator:Alexeev
Tatiana - Conferenţiar
universitar
2.
Definiție• Tusea convulsivă este o boală infecțioasă acută
determinată de cocobacilul Bordetella pertussis.
Transmisă pe cale aeriană și caracterizată clinic
prin accese paroxistice de tuse spasmodică,
precedate de o inspirație zgomotoasă.
2
3.
EtiologiaTusea convulsivă este cauzată de bacteria
Bordetella pertussis, un cocobacil
gram-negativ strict aerob, care
colonizează mucoasa tractului respirator
superior.
Caracteristicile agentului patogen:
• Este exclusiv uman, neavând rezervor
animal.
• Se transmite pe cale aeriană, prin
picături Flügge, de la o persoană
infectată.
• Prezintă factori de virulență
importanți, care determină severitatea
bolii:
Toxina pertussis – afectează celulele epiteliale
ciliate și inhibă răspunsul imun.
Hemaglutinina filamentară și pertactina – ajută
la aderența bacteriei pe mucoasa respiratorie.
Citotoxina traheală – distruge cilii respiratori,
favorizând acumularea de mucus și tusea
paroxistică.
3
4.
Structura antigenica• B.pertussis posedă 8 aglutinogeni
• Se cunosc 4 serotipuri:
I (1,2,0)
II (1,0,3)
III (1,2,3)
IV (1,0,0)
• Variantele I,IV se depistează la cei vaccinaţi şi
cu forme atipice usoare.
• Variantele II, III, se depisteaza la cei nevaccinaţi
cu forme severe si medii
4
5.
EpidemiologieSursa de infecţie
• - bolnavii cu forme tipice şi atipice
• - purtătorii sănătoşi (in focar)
Transmiterea bolii:
• - cale aerogenă (picături, contact direct cu
pacientul)
• - indirect (prin obiecte contaminate) este
rara!
5
6.
Epidemiologie• Contagiozitatea pacientului - 25 zile.
• Receptivitatea:
copii de virsta precoce 3-6 ani,
copii pîna la 1 an şi nou-născuţii.
• Indexul de contagiozitate la cei nevaccinati 0,70,8 (70-80%).
• Sezonalitate: toamna-iarana.
• Periodicitate: fiecare 2 ani.
• Imunitate: durabila pe viaţă.
• Letalitatea: pină la 0,01:1000.
6
7.
Patogenie7
8.
89.
Forme clinice9
10.
Tabloul clinic al tusei convulsive• Evoluția tusei convulsive se desfășoară în patru perioade
distincte:
• 1. Perioada de incubație (3-14 zile)
• Asimptomatică, fără semne clinice evidente.
• Bacteria se multiplică la nivelul epiteliului respirator.
• 2. Perioada catarală (1-2 săptămâni)
• Simptome asemănătoare unei viroze:
• Rinoree (secreții nazale apoase).Strănut, febră moderată sau
absentă.Tuse seacă, ușoară, care se agravează
progresiv.Pacientul este foarte contagios în această fază.Copilul
pierde pofta de mâncare , se derenglează somnul. Apare
paliditatea tegumentelor, hiperemia conjuctivelor , edemul
palpebral , în plămâni raluri uscate și umede.
10
11.
• 3. Perioada convulsivă (2-6 săptămâni) Caracterizată de accesde tuse paroxistică, urmată de o inspirație zgomotoasă
(„whoop”).Accesele de tuse:Apar mai frecvent noaptea.Sunt
urmate de cianoză, vărsături sau hipoxie.Pot duce la hemoragii
subconjunctivale, epistaxis sau hernii din cauza efortului
intens.Starea generală rămâne relativ bună între episoade.
Accesul de tuse se termină cu expectorația dificilă a unei
cantități de mucus vâscos și cu vomitări. Accesul durează 1-5
minute.Numărul acceselor in 24 h este de 10-15 cicluri
• 4. Perioada de convalescență (2-4 săptămâni sau mai mult)
• Tusea scade progresiv în intensitate și frecvență.Pacientul nu
mai este contagios, dar rămâne vulnerabil la infecții respiratorii
secundare.
11
12.
1213.
1314.
Complicații14
15.
Diagnosticul15
16.
Diagnosticul diferențialDiagnostice diferențiale ale tusei convulsive
1. Infecții respiratorii virale (adenovirus, virus sincițial respirator,
gripă, paragripă) – tuse mai puțin intensă, fără accese paroxistice
specifice.
2. Bronșita acută – tuse productivă, fără inspirația zgomotoasă
(„whoop”).
3. Pneumonia atipică (Mycoplasma pneumoniae, Chlamydia
pneumoniae) – febră mai ridicată, raluri la auscultație.
4. Tuberculoza pulmonară – tuse cronică, transpirații nocturne, scădere
în greutate.
5. Refluxul gastroesofagian – tuse nocturnă, agravată după mese.
6. Astmul bronșic – wheezing, dispnee, răspuns la bronhodilatatoare.
7. Corpul străin în căile respiratorii – debut brusc, stridor, absența
febrei.
8. Laringotraheobronșita (crupul viral) – tuse lătrătoare, disfonie,
stridor inspirator
16
17.
Tratamentul:• Copiii cu forme ușoare se trataează la domiciliu , iar cei din colectivități
mari și cu forme moderate spre severe sunt internați.
Regimul alimentar și îngrijirea pacientului
• Se recomandă evitarea stimulilor externi care pot declanșa accese de
tuse.
• Alimentația trebuie să fie:
• Bogată în calorii și vitamine
• Repartizată în mese mici și frecvente
1. Tratamentul etiologic
• Antibioterapia este eficientă doar în perioada catarală și în primele
zile ale perioadei convulsive.
• Se recomandă antibiotice precum:
• Ampicilina
• Macrolide (claritromicină, azitromicină)
• Cefalosporine de generația II și III
• Administrarea se face în doze conforme vârstei, timp de 7-10 zile.
• După perioada convulsivă, antibioticele nu mai au utilitate.
17
18.
Tratamentul patogenicSe administrează medicamente pentru reducerea hiperexcitabilității nervoase:
• Sedative: diazepam, fenobarbital
• Antihistaminice
În formele asfixice, cu apnee, se corectează hipoxia prin:
• Oxigenoterapie
• Respirație mecanică
• Drenaj postural
• Aspirația secrețiilor din căile respiratoria
În formele severe, se indică corticosteroizi timp de 4-5 zile:
• Hidrocortizon: 5-7 mg/kg corp/24h
• Prednisolon: 1-3 mg/kg corp/24h
Se administrează și preparate care:
• Lichefiază sputa
• Ameliorează respirația
• Au efect spasmolitic (eufilină)
• Suplimente vitaminice (A, C, K)
18
19.
1920.
Prognostic• Prognosticul este rezervat la copiii în vârstă de
până la 1-2 ani. Cazuri letale se înregistrează la
copiii primului an de viață (1% și mai mult). În
unele cazuri se înregistrează sechele
importante. La copiii mari prognosticul este
favorabil.
• Sechele:bronșiectazii,bronșite și pneumonii
cronice,emfizem pulmonar, defecte psihice,
sindrom epiteliform ,ticuri,derengleri de
vorbire etc.
20
21.
ProfilaxiaProfilaxia specifică (vaccinarea) se efectuează din 1959 cu
trivaccinul DTP(difterie,tetanos,pertussis).
Primovaccinarea constă în administrarea a 3 doze de
vaccin a câte 0,5 ml fiecare la intervale de 60 de zile,
începând cu vârsta de două luni. Revaccinarea se
efectuează după 18 luni de la primovaccinare,
administrând o doză de 0,5 ml vaccin DTP.
• Bolnavii se izolează pentru 25-30 de zile (în condiții de
antibioterapie pe 10-14 zile) de la debutul bolii. Pentru
copiii în vârstă de până la 7 ani, care au contactat cu
bolnavii de tuse convulsivă și nu au suportat boala, se
instalează carantină pe un termen de 14 zile din
momentul ultimului contact. În focare de tuse convulsivă
se iau măsuri antiepidemice generale.
21
22.
Bibliografie:• 1. Boli infecțioase la copii – Galina Rusu
• 2. Protocolul clinic standardizat pentru
medicii de familie – Tusea convulsivă
• 3.TUSEA CONVULSIVĂ Protocol clinic
instituțional
• 4.Imagini -Google
22
23.
Caz clinicDate de identificare:
Nume: A P
Vârstă: 3 ani
Sex: Masculin
Greutate: 13 kg
Înălțime: 95 cm
Istoric medical: Fără antecedente medicale relevante, vaccinări la zi conform vârstei.
Motivul prezentării: A a fost adus de părinți la camera de gardă din cauza unei tuse persistente, care s-a agravat în ultimele 3
zile, asociată cu episoadede dificultăți respiratorii.
Anamneza:
În urmă cu aproximativ 10 zile, copilul a început să prezinte o tuse ușoară, care a evoluat treptat într-o tuse severă,
convulsivă, mai ales noaptea.
Tusea este descrisă ca având un caracter paroxistic, urmată de un inspir rapid și zgomotos (ca un "strigăt de leu"), iar la
final apare o expirație dificilă cu o ușoară emisie de spută vâscoasă.
Nu sunt menționate episoade de febră în primele zile, însă, în ultimele 24 de ore, părinții au observat o ușoară febră de
37,8°C, dar fără modificări semnificative ale stării generale.
La examinarea fizică inițială, copilul este alert, însă ușor agitat, mai ales în timpul episoadelor de tuse. Saturația de
oxigen este 96% în aer atmosferic.
Istoricul familial și de mediu:
Nu există cazuri de tuse convulsivă în familie.
Părinții sunt nefumători și locuiesc într-o zonă urbană, fără expunere semnificativă la poluare.
Copilul a fost vaccinabil conform calendarului național de vaccinare, inclusiv vaccinul hexavalent, însă părinții
menționează că la 2 ani, Andrei a ratat programul de vaccinare DTP (diftero-tetano-pertussis).
Examinare fizică:
Temperatura: 37,8°C
Frecvența cardiacă: 112 bătăi/min
Frecvența respiratorie: 24 respirații/min
Saturatie oxigen: 96%
Inspecție: Copilul prezintă semne de oboseală post-tuse convulsivă, cu ușoare semne de cianoza peri-orală după un
episod de tuse intensă.
Palpatie: Fără semne de durere la palparea toracică. Laringe ușor iritat, fără semne de edem.
23
Auscultație pulmonară: Râgâieli fine și expirație prelungită.
24.
Diagnostic diferențial:Tusea convulsivă (Pertussis)
Infecții virale (ex. rinovirus, virus gripal)
Astm bronșic
Bronșiolită
Pneumonie bacteriană
Investigații:
1. Examen clinic: Confirma ipoteza de tuse convulsivă prin semnele caracteristice de tuse paroxistică,
inspirul rapid și zgomotos.
2. Test rapid PCR pentru Bordetella pertussis: Pozitiv.
3. Examenul sputei: Fără semne de infecție bacteriană asociată.
4. Hemoleucograma: Număr normal de leucocite, cu ușoare creșteri ale limfocitelor, ceea ce sugerează
o infecție virală sau bacteriană recentă.
5. Radiografie toracică: Normală, fără semne de consolidare pulmonară.
Tratament:
Antibiotic: Azitromicină (pentru tratamentul infecției cu Bordetella pertussis).Eritromicina,
Amoicilina
Măsuri de susținere: Hidratare adecvată, aerisire a încăperii, poziționare antireflux în timpul
episoadelor de tuse.
Tratament simptomatic: mucaltin(mucolitice),butamirate sirop(antitusiv)
Evoluție și recomandări: Andrei a fost monitorizat în spital pentru 24 de ore, iar în urma
tratamentului antibiotic, tusea paroxistică s-a diminuat semnificativ. Familia a fost informată despre
riscurile transmiterii bolii și au fost îndrumați să urmeze un program de vaccinare corect, iar Andrei a
fost recomandat să fie izolat pentru a preveni răspândirea infecției.
Concluzie: Diagnosticul final a fost tuse convulsivă (pertussis), confirmată prin testul PCR.
Tratamentul cu azitromicină a fost eficient, iar prognosticul este favorabil având în vedere vârsta și 24
starea generală a copilului. Se recomandă urmărirea post-tratament pentru eventuale complicații.
25.
•Multumescpentru
atenție!
25

medicine
medicine








